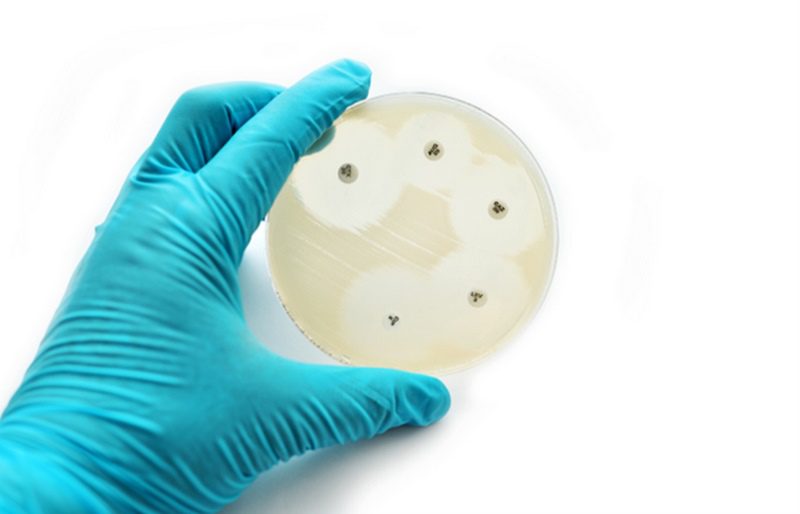

عوامل ضد میکروبی موادی هستند که رشد میکروارگانیسمها را متوقف میکنند و جهت پیشگیری و درمان بیماریهای عفونی در انسان و حیوانات استفاده میشوند. این دسته مواد بر اساس نوع ارگانیسم هدفشان تقسیمبندی میشوند و شامل آنتیبیوتیکها، ضد ویروسها، ضد قارچها و ضد انگلها میباشند.

تعریف مقاومت میکروبی
مقاومت ضدمیکروبی (Antimicrobial Resistance) یکی از چالشهای جدی سلامت عمومی در قرن بیست و یکم می باشد. منظور از مقاومت ضدمیکروبی یا AMR توانایی میکروارگانیسمها مثل باکتریها، ویروسها، قارچها و انگلها برای خنثی کردن یا بیاثر کردن داروهاست. نتیجه این امر میتواند بیماریهای سختتر، طولانیتر، پرهزینهتر و حتی غیرقابلدرمان باشد. در نتیجه مقاومت دارویی، آنتیبیوتیکها و سایر داروهای آنتیمیکروبیال بیاثر میشوند و درمان عفونتها دشوار یا غیرممکن میگردد، که این امر خطر گسترش بیماری، بیماری شدید، ناتوانی و مرگ را افزایش میدهد.
مقاومت آنتیمیکروبیال و اثرات آن بر انسان و حیوانات
مقاومت آنتیمیکروبیال هم انسانها و هم حیوانات را تحت تأثیر قرار میدهد و همچنین میتواند از حیوانات به انسانها از طریق زنجیره غذایی یا تماس مستقیم منتقل شود.
برخی میکروارگانیسمها میتوانند در برابر چند دسته دارویی مختلف مقاوم شوند که به آنها مقاومت چند دارویی (Multipledrug resistance) یا MDR میگویند. چنین ارگانیسمهایی معمولا مشکلات جدی در درمان ایجاد میکنند چرا که گزینههای درمانی را محدود میکنند، طول درمان را بیشترمیکنند و احتمال اتقال مقاومت را افزایش میدهند. در مقابل برخی میکروارگانیسمها هیچ نشانه ای را از مقاومت آنتی بیوتیکی نشان نمیدهند و به آنها میکروارگانیسم کاملا حساس (Completely Susceptible) یا (CS) میگویند.

چرا مقاومت ضد میکروبی مهم است؟
پدیدار شدن عوامل بیماریزای مقاوم به دارو مشکلساز است، زیرا این پدیده توانایی ما را در درمان عفونتها و حتی عفونتهای شایع کاهش میدهد. مقاومت ضد میکروبی پدیدهای چندوجهی است و بروز آن بر انسانها، حیوانات و محیطزیست تأثیر میگذارد. هنگامی که مقاومت ضد میکروبی در باکتریهای زئونوز (باکتریهای مشترک بین حیوان و انسان) رخ دهد، ممکن است درمان مؤثر بیماریهای عفونی در انسانها را نیز بهدلیل انتقال این باکتریها و تبادل ژنهای مقاومت میان آنها و باکتریهای بیماریزای انسانی به خطر اندازد.

دلایل اهمیت مقاومت آنتیبیوتیکی به شرح زیر است:
۱. عفونتهای مقاوم درمان را دشوار یا غیرممکن میکنند
داروهای استاندارد کارایی خود را از دست میدهند و باید از داروهای قویتر، گرانتر یا پرعارضهتر استفاده کرد.
۲. افزایش مرگومیر
با افزایش مقاومتهای آنتی بیوتیکی ممکن است عفونتهای ساده که قبلاً بهراحتی درمان میشدند دوباره مرگبار شوند.
۳. افزایش هزینههای درمانی
بیمارستانها و مراکز درمانی مجبور به استفاده از داروهای گران، بستری طولانیمدت و مراقبتهای ویژه میشوند.
۴. تهدید برای جراحیها و درمانهای پزشکی پیشرفته
بسیاری از عملهای جراحی و درمانهای سرطان به آنتیبیوتیکها وابستهاند و مقاومتهای آنتی بیوتیکی میتواند این درمانها را با خطر جدی مواجه کند.
۵. تهدید برای امنیت غذایی
مصرف بیرویه آنتیبیوتیک در دام و طیور منجر به ظهور میکروبهای مقاوم میشود که میتوانند به انسان منتقل شوند.

دلایل بروز مقاومت آنتی بیوتیکی
استفاده از عوامل ضد میکروبی در انسان و حیوان هر دو میتواند به افزایش مقاومت ضد میکروبی کمک کند. این مقاومت میتواند از طریق محیطزیست، افراد جامعه، صنعت دام و طیور و بیمارستانها گسترش یابد:
حضور باکتریهای مقاوم در محیطزیست
محیط زیست، منبع مهمی برای انتشار مقاومت آنتیبیوتیکی است. استفاده از کود های آلی و آب های آلوده به آنتی بیوتیک ها، باکتری های مقاوم را به آب و خاک منتقل می کند.

استفاده از آنتیبیوتیکها در جامعه
تجویز نادرست : مصرف آنتیبیوتیک برای بیماریهای ویروسی یا بدون تشخیص صحیح باعث ایجاد باکتریهای مقاوم میشود.
خوددرمانی: وقتی افراد بدون دستور پزشک دارو مصرف میکنند، امکان وقوع مقاومت آنتی بیوتیکی را افزایش می دهند.
استفاده در صنعت دام و طیور و کشاورزی
آنتیبیوتیکها برای پیشگیری از بیماری یا افزایش رشد در دام و طیوراستفاده میشوند. این استفاده انبوه باعث ایجاد باکتریهای مقاوم در حیوانات میشود و می تواند این مقاومت را از طریق محصولات دامی مانند گوشت و تخم مرغ به انسان نیز منتقل کند.
آنتیبیوتیکها برای پیشگیری از بیماریهای گیاهی نیز استفاده میشوند که باعث ایجاد باکتریهای مقاوم در خاک و سطح گیاهان میشود.
انتقال باکتریهای مقاوم از حیوانات یا محصولات کشاورزی به انسان از طریق زنجیره غذایی یکی از مسیرهای مهم گسترش مقاومت آنتی بیوتیکی است.

استفاده در بیمارستانها
بیمارستانها محل تجمع بیماران با عفونتهای شدید هستند و استفاده طولانی از آنتیبیوتیکها باعث ایجاد باکتریهای مقاوم میشود.
در بیمارستانها، باکتریهای مقاوم به سرعت بین بیماران و محیط منتقل میشوند و مشکلات درمانی جدی ایجاد میکنند.
باکتریها در رودهی انسان و حیوانات وجود دارند و بنابراین در فضولات از جمله فاضلاب تصفیهنشده، لجن فاضلاب و کودهای آلی مانند کود حیوانی یافت میشوند. این فضولات میتوانند منجر به آلودگی آبهای سطحی، خاک و هوا در محیطهای تولید مواد غذایی شوند. در ادامه، آب، خاک و گرد و غبار موجود در هوا میتوانند بهعنوان مسیرهای انتقال مقاومت ضد میکروبی عمل کرده و سیستمهای تولید مواد غذایی را آلوده کنند.
کارگران مزارع و تجهیزات آنها میتوانند از طریق تماس مستقیم، مقاومت ضد میکروبی را به سیستمهای تولید مواد غذایی وارد کنند. تماس با حیوانات آلوده، فرآوردههای زائد آنها و مصرف مواد غذایی حاصل از آنها میتواند باعث ورودباکتری های مقاوم به جمعیت انسانی شود.